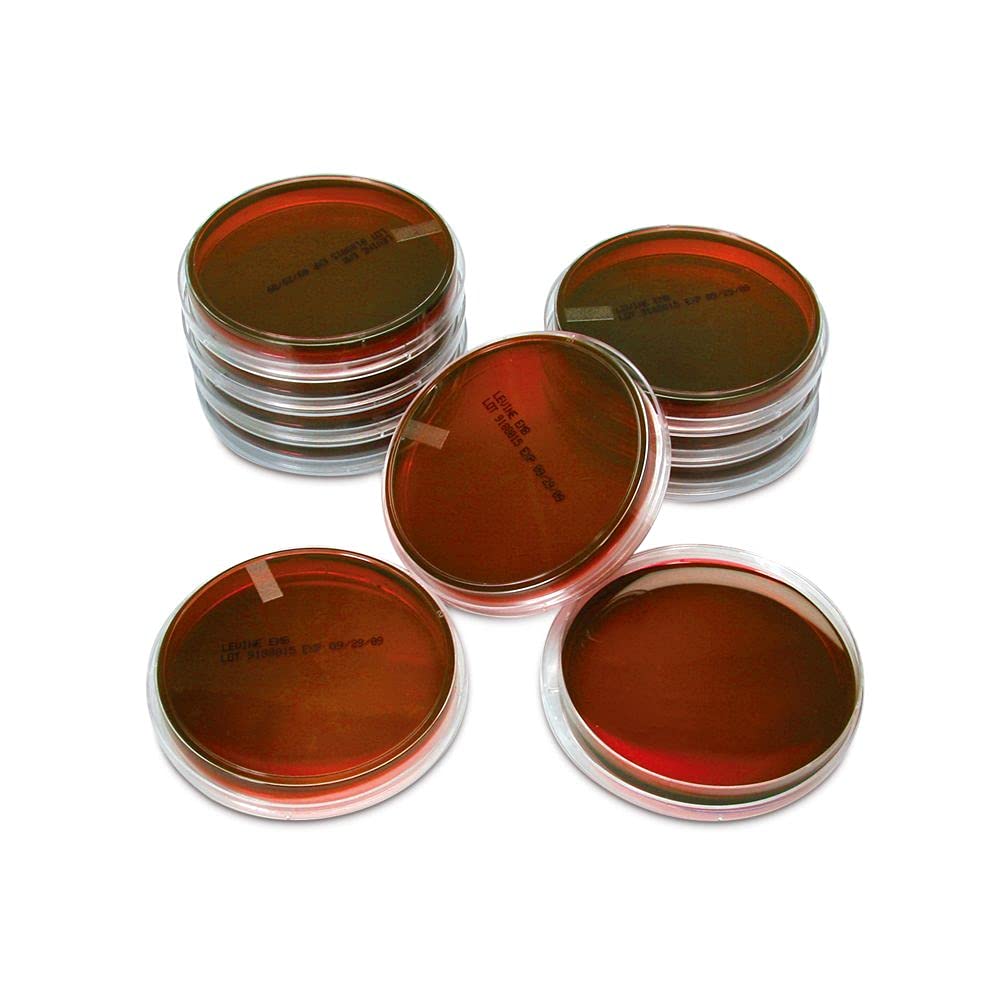
Levine Eosin Methylene Blue Agar, Prepared Media Plates, 100 x 15 mm, Pack of 10

New
Arrivals/Restock
Flamingo Vans
 Limited Time Sale
Limited Time SaleUntil the end
05
21
18
€15.20 cheaper than the new price!!
Free shipping for purchases over €99
See all stores
Please note that the sales price and tax displayed may differ between online and in-store. Also, the product may be out of stock in-store.
New €38.00
Product details
| Management number | 14553750 | Release Date | 2025/10/02 | List Price | €22.80 | Model Number | 14553750 | ||
|---|---|---|---|---|---|---|---|---|---|
| Category | |||||||||
Correction of product information
If you notice any omissions or errors in the product information on this page, please use the correction request form below.
Correction Request Form